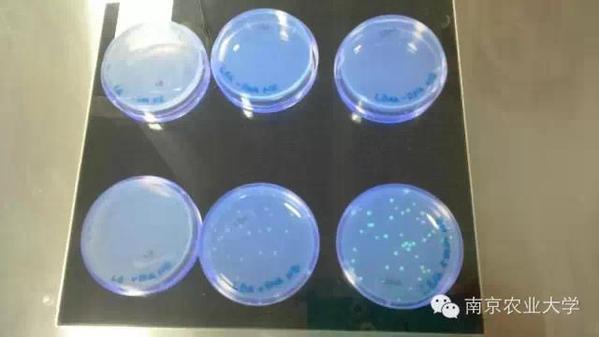

编者按:从2012年起,我校开始设立奖学金奖励品学兼优本科生赴海外高水平大学进行专业课程学习。经过学院推荐、学校审核、对方评审,本文作者最终获得了我校的全额奖学金,并于2015年初赴澳大利亚西澳大学学习一学期。奖学金额度为10万元人民币。
谈到西澳大学,我们的第一反应或许是:“这什么大学,没听说过,排名怎样啊?”事实上,西澳大学绝不容小觑。以下来自百度:
西澳大学是澳大利亚 “八校联盟”的成员之一,也是澳大利亚进入2011年QS世界前一百名校排名中仅有的五所高校的其中一员。2012年,QS世界大学排名将西澳大学列为全球排名第79名。在2007年,西澳大学全球排名为64。在2014年QS世界大学星级排行榜中,西澳大学力压群雄,荣获5星+(A truly world-class university)评价,成为世界上仅有的10所荣获此殊荣的综合性大学中的成员之一。
谈排名太抽象了,下面来具体说一说。
学校位置
西澳大位于澳大利亚西澳大利亚州的首府珀斯,学校北边是斯最大的国王公园,东南边是天鹅湖,往西开车20分钟就能到风景如画的日落沙滩,这样的地理环境足可看出珀斯把自己最好的土地用来建造最高学府。能在西澳大学交换一个学期,不能不说是莫大的荣幸。

图为天鹅湖
学校设施
温斯洛普会堂是西澳大学的标志性建筑,新生入学,毕业典礼等重要事件都会在这里举行。

图为温斯洛普会堂
校内建筑基本是英式建筑,有着短则几十年长近百年的历史。



西澳大学的校园里全面覆盖了免费快速的wifi,只有少数几个角落收不到信号。某些课的老师会要求学生做联网的课堂测试,你会看到几百个学生刷刷刷拿出电脑连网,然后开始一片此起彼伏的打字声。西澳大学共有6座图书馆,所有图书馆都设有三个区域,分别是讨论区,quiet区以及silent区,大多数人都遵守这个规则,所以想在图书馆自习的同学总能找到安静的去处。


老师授课基本都是用投影ppt,不过也会偶尔拿起笔写个板书。

学习
全日制本科生一学期只需要修四门课即可,一个星期总的课时数不超过20节。不过,学生们必须在课外花很多时间学习。通常来说一门课由lecture,workshop及tutorial组成。Lecture和国内的课堂并无二致,workshop通常是学生之间的共同协作,比如peer review和team project ,tutorial可以理解成答疑课,每个星期lecture上布置的作业都会在tutorial课上讲评。所以,我个人的情况是,好不容易看了几个小时的课本,背上书包去上lecture,勉勉强强听懂了老师讲的是什么,马上就有了新的预习作业和小组作业,在经历了对方听不懂你你也听不懂对方却能顺利完成小组作业的workshop后,又要开始准备下一节tutorial的内容。这样高强度连轴转还仅仅是一门课,所以一学期四门课并不是很轻松的一件事。
关于你所选的课的各种信息你都能在lms上找到。Lms(learning management system)是一个网络系统,上面发布着你的课程信息,包括课程架构,课程资料,考试日期,评分标准,考试成绩等等。每节lecture都会被录下来发布到lms上,这给非英语母语的学生和因故未能出席的学生带来了极大的便利。
除了课程视频录制外还有一个极其人性化的安排。Tutorial的课堂与lecture并不相同,老师是专业的tutor,只带领十几名学生,因此tutorial有很多重复的课,如果你有事去不了原来的tutorial,那就查查课表换一节课去上。
实验与实践
除了传统课程的几个模块(lecture,tutorial,workshop),如果你在西澳大学修读了理工科类课程,那么你还会有其他两种新的课程形式——practical and lab。Lab顾名思义就是实验, 西澳大学非常注重学生对实验的理解,因为老师们都认为你在lecture上学到的知识一定要转化到实际操作中,因此实验课是必须参与的,每当一个章节的内容结束后,下一周都会紧跟相应的实验,实验时长两个小时,在实验开始前,会在lms上贴出相应背景知识和题目,每个学生必须在实验前预习这些资料并且完成一次预习作业,在实验中,要与你的同学合作(往往是随机分组,非常考验团队协作能力)完成研究任务。举个在动物神经比较学(animal comparative neuroscience code:ANIM 3320)实验的例子,连续两个星期我们小组(随机分配4人)需要解剖一种未知的鱼类的,并制作其视网膜神经细胞和光感受器细胞的标本,再通过某种方式绘制这两种细胞的分布图,最终鉴定其视觉模型推断该鱼类生存环境。在这两个星期中你需要和新认识的同学一同商量步骤与方法,老师提供材料后就不会给任何指导,而是在实验过程中提出针对你们小组方法的建议,“no way is good or bad, at least you think about it.”这是老师最常说的话,不要计较是否对错,关键在于你们想出了什么方法。于是,你就会看见小伙伴们有的用电子摄像头链接显微镜,有的拿着各种颜色的马克笔直接在投影上作图,有的则选择专业软件分析……然后就恍然大悟原来还可以这么玩……最终这份结果需要写成一篇4000单词的论文,然后将初稿进行匿名的互改(peer review),加上老师的反馈,再成为终稿。
看似只是一场实验,但却是日后各种科研工作的浓缩,整个过程都是在演练拿到课题,到发表结果的每个环节。最重要的是,没有框架去模仿,所有人都要开动脑筋如果你想研究这个,应该怎么办?可行吗?得先做了才知道。正是如此,才明白可贵的创造,而不是一味的模仿和学习。
那么说了lab, practical又是什么呢?就是实践!最有代表性的是肌肉与骨骼结构功能(movement of muscle and skeleton code: SSEH1101)的实践课,竟然是在体育馆上的!还要求必须全身运动装带上眉笔!!!当时我就觉得混搭风啊 课堂上教练(其实是老师)会让大家分组想尽办法运动刚刚在课题上讲过的骨骼,肌肉或者韧带。然后如果某个同学动作正确的话,其余组员就开始拿眉笔在这位活标本上标出各种结构,然后互相讲解,如果标本累了或者已被涂鸦的惨不忍睹,好的,换下一位。一节课后大家都挂彩了,不过映像也更加深刻了。

生活
你能想象刚到不久的我在校园里漫步时碰到一只比我更信步款款的孔雀是怎样的场景吗?西澳大学有很多的鸭子,就像因为生态环境较好,很多大学校园里都有鸭子,猫之类的动物,这是我预料到的。但出乎我意料的是,这里的环境或者说人与动物和平相处的境界已经好到可以养孔雀了。
所以在这样的校园里学习生活福利是:学累了,你便可以拿一片面包(千万别乱喂东西)去艺术学院看看孔雀在不在,或者坐在大草坪上喂一大群前来捕食的鸭子,甚至可以走几步,去天鹅湖静静地望着成双成对的黑天鹅发一会儿小呆。
Work hard and play hard,当所有学习任务都已完成时,你大可以肆意地将自己放松在南半球明媚热烈的阳光下,无论是去港口餐厅点上一份炸鱼薯条,变身背包客来一趟说走就走的环岛骑行,或是预定场地约上三两好友来场挥洒汗水的友谊赛,都是你不容错过的美好生活。


